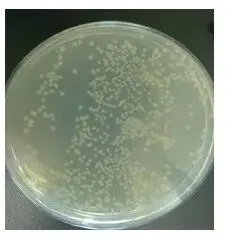
涂布平板法 涂布平板法

科研干货 | 微生物分离培养的三种方法
发布时间:2026-02-27 浏览次数:76
在微生物科研领域,分离培养是关键技术。微生物在自然环境里多以混合群体形式存在,而科研常需针对特定微生物深入研究,此时分离培养技术就很重要。其原理是利用微生物的生理生化特性差异,从而把目标微生物从混合群体中分离,常用的方法有划线分离法、涂布平板法和倾注平板法。
方法一:平板划线法
一)原理剖析
平板划线法是一种经典的微生物分离技术,其原理很简单。它是用接种环在固体培养基表面划线。把含有多种微生物的菌液用接种环蘸取后,在平板上划线,菌液会在培养基表面铺展。每次划线后,接种环上的微生物细胞数量因分散而减少,相当于稀释了一次。划线次数越多,微生物细胞越被稀释,最后分散成单个细胞。在合适的条件下,单个细胞会生长、繁殖,形成独立的单菌落。每个单菌落都是由一个单细胞繁殖而来的,理论上遗传物质相同,是纯种微生物。这样,科研人员就能从混合微生物群体中分离出目标微生物的纯培养物。

二)操作步骤详解
取菌种:从存菌种的容器里把目标菌种拿出来。要是菌种是冷冻保存的,得先在合适的地方让它慢慢恢复活性,这样才能方便后面的操作。比如说,从低温冰箱里拿出用甘油管保存的菌种后,要把它放在 37℃的水浴锅里快速解冻。
接种针灭菌冷却:一般用镍铬合金丝做的接种环来当接种针。拿这个接种环在酒精灯外焰上烧,一直烧到金属丝发红,这样能确保把可能存在的杂菌都杀死。灭完菌后,把接种环放一边,让它自己降降温,别烫死了待会儿要接的微生物。
蘸取菌种:先用 75% 的酒精棉球擦擦手,等酒精完全挥发后,在酒精灯火焰无菌区,用已经冷却的接种环蘸点菌种。操作的时候得注意,别让接种环碰到其他可能有污染的东西,得保证蘸的菌种是纯的。
划线:拿一个已经做好的固体平板培养基。在烧接种环的时候,把平板靠近酒精灯火焰稍微消消毒,这样能少沾点平板表面的杂菌。打开平板后,先把接种环上的菌种在平板一侧连续划 3 - 4 次线,先弄出一个初始的菌带。接着一边转动平板一边用酒精灯烧接种环,再次灭菌后等它冷却,然后从起始菌带末端开始,穿过之前划的线继续划。划几次得看菌液浓度和菌种类型。要是菌液浓度高,可能得多划几次,好让菌充分稀释;对于长得快、易分散的菌种,划线次数也可以变一变。划的时候,接种环要跟平板表面保持约 30° - 40° 角,力度均匀,别把培养基划破。
标记:在平板底部边缘,用记号笔清楚地写上菌种名称、接种日期,还有其他相关信息,比如实验编号、操作人这些,这样后面能方便识别和管理平板。
培养:划好线的平板倒着放进恒温培养箱里,按目标微生物适合的生长温度来培养。把平板倒着放,是为了防止培养时产生的冷凝水滴到培养基表面,影响菌落生长和形态,也能少点杂菌污染的可能。
保存:培养好了,要是暂时不用平板上的菌种,就把它放进 4℃的冰箱里存着。保存的时候要注意把平板密封好,防止水分蒸发和杂菌污染。
三)操作技巧与注意事项
接种环要烧一烧:每次划线前后都要用酒精灯把接种环烧红,这样才能把上面残留的微生物都灭掉。烧完后,得等接种环变凉了再接着操作,不然高温会把菌种烫死,实验就白费了。
操作得无菌:平板划线整个过程要讲究无菌,最好在超净工作台里弄。要是没有超净工作台,就在酒精灯火焰旁边操作,这样能少沾点杂菌。操作的时候,手别乱碰平板里面和接种环前端接触菌种、培养基的地方。
力度要适中:划线的时候别太用力,不然会把培养基划破。要是培养基破了,菌落长不好,分布也不均匀,而且不同区域的微生物会混在一起,就达不到分离的效果了。
平板得挑挑处理处理:选平板培养基时,表面要干燥、硬度合适。要是平板上有水珠,微生物分布就不均匀,不利于单菌落形成。刚倒好的平板如果有冷凝水,可以倒置在 37℃培养箱里放一会儿,让水分蒸发。
标记要清楚:标记信息一定要写清楚、准确,不然容易混。要是标记模糊,后续实验里就分不清菌种和相关情况,会影响实验进行和结果分析。
方法二:涂布平板法
一)技术原理
涂布平板法主要是根据微生物在合适环境里能生长的特点来的。先要对要分离的微生物样本做梯度稀释,这么做就是想让样本里的菌体尽量分开,变成一个个单独的细胞。稀释的次数越多,样本里的微生物细胞就越来越稀。等稀释到一定程度,原本聚在一起的微生物细胞就被分开了。接着把不同稀释程度的菌液均匀地涂在固体培养基上,这样每个单细胞在培养基上都有机会独自生长、繁殖。在合适的温度、湿度等条件下养一段时间,这些单细胞就会不断分裂繁殖,最后形成一个个能用肉眼看到的单菌落。因为每个单菌落都是由一个单细胞繁殖出来的,所以从理论上讲,每个菌落都代表了一个纯的微生物菌株,这样就能把微生物给分离出来了。而且还能通过数平板上的菌落数量,再结合稀释的倍数和涂布时用的菌液体积,算出样本里微生物的数量,所以涂布平板法既可以用来分离微生物,还能做定量分析,是比较实用的一种方法。
二)梯度稀释与涂布操作流程
称量样品和初步稀释:称 10g 待测样品,比如土壤样品,放到有 90ml 无菌水和小玻璃珠的 250ml 三角瓶中。小玻璃珠能在振荡时让微生物细胞分散得更好。把三角瓶放摇床上摇 20 分钟,让微生物细胞充分分散在无菌水里,这就得到了 10⁻¹ 稀释液。摇完后,静置 20 - 30 秒,让大的颗粒沉下来。
继续稀释:用 1ml 无菌吸管取 1ml 10⁻¹ 稀释液,放入有 9ml 无菌水的试管中,用吸管反复吹吸 3 次,混匀后得到 10⁻² 稀释液。换支无菌吸管,取 1ml 10⁻² 稀释液,放入有 9ml 无菌水的新试管,同样吹吸 3 次,得到 10⁻³ 稀释液。依此类推,得到不同稀释度的菌液。每次换稀释度都要换新吸管,防交叉污染。
标记平板:准备些无菌平板,在底部用记号笔写上对应稀释度,比如 10⁻³、10⁻⁴、10⁻⁵ 等,也可以写样品名、实验日期等,方便后续识别和管理。
涂布菌液:用无菌吸管取 0.1ml 不同稀释度的菌液,分别滴到对应平板培养基上。用无玻璃菌刮刀(涂布棒)涂匀。先在酒精灯上烧玻璃刮刀灭菌,冷却后再涂布。从低浓度开始,涂完一个平板,再烧刮刀灭菌。涂的时候,刮刀和平板表面呈 30° - 40° 角,轻轻匀速涂开,别用力过猛划破培养基。
培养:涂好菌液的平板倒着放恒温培养箱里,按目标微生物的生长特性设合适温度和时间。比如,多数细菌在 37℃培养 24 - 48 小时,真菌在 25℃左右培养 3 - 5 天。倒置平板能防止冷凝水滴落,影响菌落生长和形态,还能减少杂菌污染。
计数和保存:培养结束后,取平板,选菌落数在 30 - 300 个的平板计数。统计菌落数,记录每个平板的数据。多个合格平板就算平均值。按公式 “每克样品菌株数 = (平板菌落数 ÷ 涂布稀释液体积)× 稀释倍数” 算微生物数量。计数完,若要保存平板菌种,密封后放 4℃冰箱保存。
三)计数原则与应用
计数原则:涂布平板法里,平板上有 30 - 300 个菌落时,计数结果比较准。菌落太少,样本量小误差大;太多,菌落易重叠,都不好算。如果只有一个稀释度的平均菌落数在 30 - 300 之间,就用这个数除以涂布体积(一般是 0.1ml),再乘以稀释倍数,就是样品的细菌总数。比如,平板上有 150 个菌落,用的是 10⁻⁴ 稀释度的菌液,涂布体积 0.1ml,那细菌总数就是(150÷0.1)×10⁴=1.5×10⁷ 个/g(假设样品 1g)。如果有两个稀释度的平均菌落数都合适,就看它们菌落总数的比值。比值小于 2,取平均值;大于 2,取较小的数。比如,10⁻⁴ 稀释度平板上 120 个菌落,10⁻⁵ 的上 100 个,比值 1.2 小于 2,那细菌总数就是 [(120÷0.1)×10⁴ +(100÷0.1)×10⁵]÷2=6.1×10⁷ 个/g 。
应用场景:涂布平板法在微生物领域用处多。在食品微生物检测上,能测食品中微生物数量,看卫生质量和安不安全。像测牛奶细菌总数,就能知道污染情况,判断是否达标。在环境微生物研究里,能分析土壤、水体等环境样品中的微生物群落结构和数量变化。分离计数不同环境里的微生物,能研究环境因素对它们的影响,给环境监测和生态保护做数据支持。在工业微生物发酵时,能监测发酵液中微生物生长,优化条件,提高效率和质量。比如酿酒,测发酵液中酵母菌数量,保障发酵正常。
方法三:倾注平板法
一)工作原理
倾注平板法的原理其实就是利用微生物能生长的特点,再加上稀释涂布的基本思路。先对微生物悬液进行逐步稀释,稀释的目的就是把微生物细胞分开来,让它们不至于太挤。稀释好之后,取少量稀释后的悬液,跟已经化开又冷却到45 -50℃的无菌营养琼脂培养基混在一起,这个温度刚刚好,培养基还是液态,能和菌液充分混匀,又不会烫死微生物。接着把混合液赶紧倒进无菌培养皿里,等培养基凝固了,微生物细胞就被固定在培养基里或者表面上了。在合适的温度、湿度条件下,微生物细胞就开始生长、繁殖,分裂了好多次之后,就能长出肉眼能看到的菌落。一个菌落就是一个细胞繁殖出来的,理论上每个菌落都是纯种微生物。要是挑出单个菌落,再做成新的微生物悬液,重复之前的那些步骤,比如稀释、混合、倒平板,重复几次,就可以把杂菌去掉,得到更纯的培养物了。

二)操作流程与要点
配培养基:按目标微生物的要求选合适的培养基配方。比如培养大肠杆菌,用 LB培养基就行。把配好的培养基装进三角瓶,塞紧棉塞,包好后放高压锅里灭菌。在 121℃下灭 15 - 20 分钟,把培养基里的微生物和芽孢都杀死。灭完菌的培养基放 45 - 50℃的水浴锅预热,保持液态,方便和菌液混合。
标记培养皿:在超净工作台这种无菌地方,取无菌培养皿,用记号笔在底部写上培养基名字、菌液稀释度、接种日期、样品编号等信息,方便后面区分和管理。
接种菌液:用无菌移液枪或吸管,吸 1ml 经过梯度稀释的微生物悬液,放到空培养皿中央。注意移液器具前端别碰培养皿边缘等可能被污染的地方,保证菌液纯净。
倒培养基:从水浴锅取出预热好的培养基,右手握三角瓶瓶颈,在酒精灯火焰上快速烧一下瓶口灭菌,防止杂菌污染。然后快速把培养基倒进有菌液的培养皿中央,倒 15 - 20ml,让培养基能盖住整个菌液,在培养皿里形成合适厚度。
混合培养基:倒完培养基后,马上双手握住培养皿,轻轻顺时针和逆时针交替转,让菌液和培养基混匀。转的时候速度和力度要合适,别产生太多气泡,也别用力过猛让培养基溢出,同时要快点操作,防止培养基凝固。
等培养基凝固:把混合好的培养皿放平,静置等培养基凝固。过程中别动培养皿,以免影响培养基平整度和菌落分布。一般室温下 15 - 30 分钟就能凝固。
培养:凝固后,把培养皿倒着放恒温培养箱里,按微生物生长条件培养。多数细菌在 37℃培养 24 - 48 小时,真菌在 25℃左右培养 3 - 5 天。倒置培养皿能防止冷凝水滴落,影响菌落生长和形态,也能少杂菌污染。
计数和挑单菌落:培养结束后,取培养皿,选菌落数在 30 - 300 个的平板计数,记录菌落数。要纯培养物的话,用无菌接种环挑平板上形态典型、孤立的单菌落,接种到新的液体或斜面培养基培养。挑菌落时,让接种环只接触目标菌落,别碰周围杂菌。
重复操作:把挑取的单菌落制成新的微生物悬液,再做梯度稀释、混合培养基、倾注培养等操作,重复 2 - 3 次,提高微生物纯度,确保得到纯种培养物。
三种方法的比较与选择
这三种微生物分离培养法各有特点,科研人员会根据实验需求和条件选择合适的方法。
操作难度上,平板划线法最简单,步骤少,要求低,易上手;涂布平板法复杂些,得梯度稀释、无菌操作,对技巧和耐心要求高;倾注平板法最繁琐,需梯度稀释、控温,操作稍有不慎就影响结果。
适用场景方面,平板划线法适合分离要求高的实验,如从混菌中分离纯种,用于鉴定等;涂布平板法常用于计数和筛选;倾注平板法适用于初步估计数量和分离对热不敏感微生物。
分离效果上,平板划线法操作得当分离效果好;涂布平板法通常较好且易控制;倾注平板法受限多,但多次操作也能纯化。
计数能力方面,平板划线法一般不能计数,涂布和平注法都能计数,但涂布法更准确。
